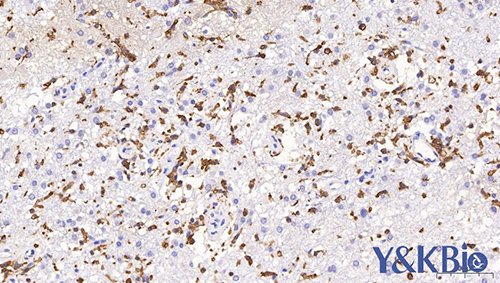

新闻动态
联系我们
陕西依科生物技术服务有限公司陕西依科生物技术服务有限公司免费为您提供{黑龙江全景数字扫描},{黑龙江荧光扫描},{黑龙江白光扫描}等一些相关信息的展示发布,请您关注本站!
1.抗体浓度过高:一抗浓度过高是常见的原因之一。解决办法是,每次使用新抗体前应当对其工作浓度进行测试,使每一抗体个体化,找到适合自己实验室的理想工作浓度,既使是即用型的抗体也应如此,不能只简单的按说明书进行染色。
2.抗体孵育时间过长或温度较高:解决办法是,严格执行操作规程,最好随身佩带报时表或报时钟,及时提醒,避免因遗忘而造成时间延长。现在流行的二步法(Polymer)敏感性很高,要求一抗孵育的时间不是传统的 1 h,而是 30 min,因此,要根据染色结果进行调整。
3.DAB 变质和显色时间太长:DAB 最好现用现配,如有沉渣应进行过滤后再用。配制好的 DAB 不应存放时间太长,因为在没有酶的情况下,过氧化氢也会游离出氧原子与 DAB 产生反应而降低 DAB 的效力,未用完的 DAB 存放在冰箱里几天后再用这种似乎节约的办法是不可取的。
DAB 的显色最好在显微镜下监控,达到理想的染色程度时立即终止反应。不过当染色片太多时或用染色机时,这样做似乎不现实,但至少应对一些新的或少用的抗体显色时进行监控,避免显色时间过长。
4.组织变干:修复液溢出后未及时补充液体、染色切片太多、动作太慢、忘记滴液、滴液流失等都是造成组织变干的原因。解决的办法是操作要认真仔细,采用组化笔在组织周围画圈,可以有效的避免液体流失,也能提高操作速度。
5.切片在缓冲液或修复液中浸泡时间太长(大于 24 h):原因上不清楚,但现象存在。有的实验室喜欢前一天将切片脱蜡至修复,第二天加抗体进行免疫组化染色,如果将装有切片和修复液的容器放在 4ºC 冰箱过夜,对结果无明显影响,如果放在室温,特别是炎热的夏天,会出现背景着色,因此,不可存放时间太长。
6.一抗变质、质量差的多克隆抗体:注意抗体的有效期,过期的抗体要么不显色要么背景着色。用新买的抗体时最好设立阳性对照和用使用过的抗体作比较。
{陕西依科生物技术服务有限公司}口碑怎么样?{黑龙江全景数字扫描}哪里好?{黑龙江荧光扫描}找哪家?陕西依科生物技术服务有限公司专业从事{生物科研试剂的研发、销售及相关技术服务}